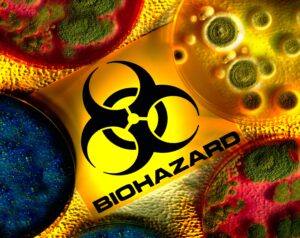

(855) 742-7773
Whether a small dental office or a healthcare facility, all these places need a trusted partner to assist them with medical waste disposal. Amarillo Biomedical Waste Disposal is the most trusted partner in Amarillo, TX offering healthcare facilities, laboratories and dental offices safe and compliant medical waste disposal. With our specialized services in handling, transportation and disposal of medical waste, your business will be compliant with all local, state and federal laws.
Why Proper Biomedical Waste Disposal Matters
Correct disposal methods must be used when dealing with medical waste to ensure safety from health hazards and environmental damage. We mitigate waste-related safety issues by protecting your staff, patients, and the public from disease and contamination while minimizing environmental threats.
Our Services
- Medical Waste Collection & Disposal – Safe disposal of regulated medical waste along with scheduled pickups is offered.
- Sharps Disposal – Needles and other sharp instruments such as syringes are securely collected and disposed of.
- Biohazardous Waste Handling – Proper management of infectious materials with the potential of causing contamination is offered.
- Pharmaceutical Waste Disposal – Expired strategic chemicals are safely removed to minimize misuse and destruction of the environment.
- Flexible Pickup Schedules – Tailored services to fit the needs of clients including daily, weekly and monthly pickup services.
Who We Serve
- Hospitals & Clinics
- Dental Clinics
- Nursing & Assisted Living Homes
- Veterinary Hospitals
- Laboratories
- Tattoo Studios and Med Spas
Why Choose Amarillo Biomedical Waste Disposal?
- Compliance & Safety – We follow OSHA, EPA, and Texas state guidelines.
- Cost Effective & Clear Pricing – No extras, only honest, low-priced services.
- Environmental Responsibility – Our company policy is to reduce pollution through the use of green technology.
- Dependable & Quality Services – Your waste is managed by trained professionals, ensuring proper care and efficient handling.
Get A Free Quote Today – Amarillo Biomedical Waste Disposal
If you need an efficient biomedical waste disposal service in Amarillo, TX, we’re ready for your call. Reach out to Amarillo Biomedical Waste Disposal for a no obligation consultation and let us help you manage your medical waste in a responsible manner.